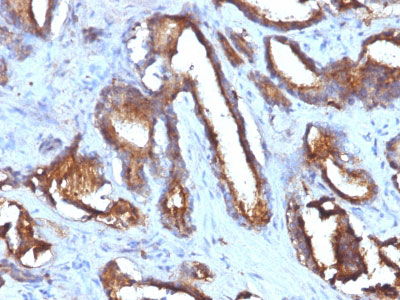

> Antigen, Antibodies, ELISA, Western Blot > Primary Antibody > Monoclonal Antibodies > CD63 (Late Endosomes Marker) Antibody - Without BSA and AzideBrand |
Leading Biology | Catalog Number |
AMM01617G |
Product Type |
Monoclonal Antibodies | Field of Research |
|
Product Overview |
We constantly strive to ensure we provide our customers with the best antibodies. As a result of this work we offer this antibody in purified format.
We are in the process of updating our datasheets. If you have any questions regarding this update, please feel free to contact our technical support team.
This product is a high quality CD63 (Late Endosomes Marker) Antibody - Without BSA and Azide.
|
||
Molecular Weight |
26kDa (core protein); 30-60kDa (glycosylated)
|
||
Cellular Localization |
Antigen Cellular Localization:
Cell membrane; Multi-pass membrane protein. Lysosome membrane; Multi-pass membrane protein. Late endosome membrane; Multi-pass membrane protein. Endosome, multivesicular body. Melanosome. Note=Also found in Weibel-Palade bodies of endothelial cells. Located in platelet dense granules. Detected in a subset of pre-melanosomes. Detected on intralumenal vesicles (ILVs) within multivesicular bodies
|
||
Host |
Mouse
|
||
Species Reactivity |
Human
|
||
Clone |
NKI/C3 + LAMP3/968
|
||
Isotype |
Mouse / IgG's
|
||
Symbol |
MLA1, TSPAN30
|
||
GeneID |
|||
UniProt ID |
|||
Function |
Functions as cell surface receptor for TIMP1 and plays a role in the activation of cellular signaling cascades. Plays a role in the activation of ITGB1 and integrin signaling, leading to the activation of AKT, FAK/PTK2 and MAP kinases. Promotes cell survival, reorganization of the actin cytoskeleton, cell adhesion, spreading and migration, via its role in the activation of AKT and FAK/PTK2. Plays a role in VEGFA signaling via its role in regulating the internalization of KDR/VEGFR2. Plays a role in intracellular vesicular transport processes, and is required for normal trafficking of the PMEL luminal domain that is essential for the development and maturation of melanocytes. Plays a role in the adhesion of leukocytes onto endothelial cells via its role in the regulation of SELP trafficking. May play a role in mast cell degranulation in response to Ms4a2/FceRI stimulation, but not in mast cell degranulation in response to other stimuli.
|
||
Summary |
This MAb recognizes protein of 26kDa-60kDa, which is identified as CD63. The tetraspanins are integral membrane proteins expressed on cell surface and granular membranes of hematopoietic cells and are components of multi-molecular complexes with specific integrins. The tetraspanin CD63 is a lysosomal membrane glycoprotein that translocates to the plasma membrane after platelet activation. CD63 is expressed on activated platelets, monocytes and macrophages, and is weakly expressed on granulocytes, T cell and B cells. It is located on the basophilic granule membranes and on the plasma membranes of lymphocytes and granulocytes. CD63 is a member of the TM4 superfamily of leukocyte glycoproteins that includes CD9, CD37 and CD53, which contain four transmembrane regions. CD63 may play a role in phagocytic and intracellular lysosome-phagosome fusion events. CD63 deficiency is associated with Hermansky-Pudlak syndrome and is strongly expressed during the early stages of melanoma progression.
|
||
Form |
Liquid |
||
Storage & Stability |
Store at +4°C short term. For long-term storage, aliquot and store at -20°C or below. Stable for 12 months at -20°C. Avoid repeated freeze-thaw cycles.
|
||
Applications |
IHC, IF, FC
|
||
Images |

Formalin-fixed, paraffin-embedded human Melanoma metastasized to Lung stained with CD63 Monoclonal Antibody (NKI/C3 + LAMP3/968) 
Formalin-fixed, paraffin-embedded human Testicular Carcinoma stained with CD63 Monoclonal Antibody (NKI/C3 + LAMP3/968)
Formalin-fixed, paraffin-embedded human Prostate Carcinoma stained with CD63 Monoclonal Antibody (NKI/C3 + LAMP3/968) |
||
Specification |
|||
Quantity |
|
||
| Select | Brand | Catalog No. | Product Name | Pack Size | Type | Field of Research | Specification | Quantity | Price(USD) | |
| 1 | Leading Biology | APG02467G | CCK4 / PTK7 Antibody (clone 4F9) | 50 μl | Monoclonal Antibodies |
|
$495.00 | Add Ask | ||
| 2 | Leading Biology | AMM04683G | GALT Antibody (clone 4C11) | 50 μg | Monoclonal Antibodies |
|
$545.00 | Add Ask | ||
| 3 | Leading Biology | AMM01402G | Vimentin (Mesenchymal Cell Marker) Antibody - With BSA and Azide | 50 ug | Monoclonal Antibodies |
|
$395.00 | Add Ask | ||
| 4 | Leading Biology | APR08280G | LTA4H / LTA4 Antibody (clone 9G8) | 50 μl | Monoclonal Antibodies |
|
$495.00 | Add Ask | ||
| 5 | Leading Biology | AMM00172G | CD1a / HTA1 (Mature Langerhans Cells Marker) Antibody - With BSA and Azide | 50 ug | Monoclonal Antibodies |
|
$395.00 | Add Ask | ||
| 6 | Leading Biology | AMM05750G | CEBPA Antibody | 100 μl | Monoclonal Antibodies |
|
$545.00 | Add Ask |
 Leading Biology Inc.
2600 Hilltop DR, Building G, B Suite C138
Richmond, CA, 94806
Tel: 1-661-524(LBI)-0262
Email: info@leadingbiology.com
Leading Biology Inc.
2600 Hilltop DR, Building G, B Suite C138
Richmond, CA, 94806
Tel: 1-661-524(LBI)-0262
Email: info@leadingbiology.com
Complete this form and click send to ask us a question, request a quote or simply say hello.

You have 0 item in your cart

You have 0 item in your inquiry list
